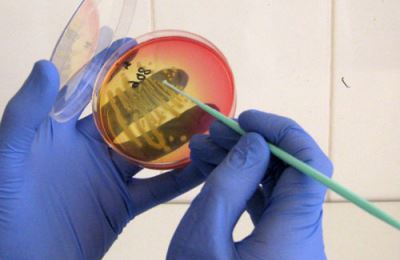

До появления антибиотиков, стрептококковая инфекция являлась огромнейшей проблемой всего населения. Как правило, обычная ангина ставала причиной для развития ревматизма и пороков в сердце.
К счастью, в наше время ревматизм встречается намного реже, но стрептококковая инфекция – также часто. Как ее распознать, лечить и предупредить, вы сможете узнать, прочитав эту статью.
Как можно заподозрить ее наличие?
Стрептококковая инфекция имеет ряд признаков, по которым можно заподозрить ее наличие. Но точно поставить диагноз, конечно, имеет возможность только врач. Чаще всего, это проблема встречается у ребенка, и нужно быть очень внимательными, чтобы не пропустить стрептококки в горле, и вовремя начать соответствующую терапию.
Ниже представлены основные ее ранние признаки:
Больной испытывает выраженную слабость во всем теле.
- Снижается аппетит, для ребенка грудного возраста характерен полный отказ от вскармливания.
- Сопли и откашливаемое имеют зеленящий цвет.
- Температура тела быстро повышается.
В случае, если гемолитический стрептококк в горле появился на фоне острого вирусного заболевания, на фоне начавшегося выздоровления резко начинает повышаться температура тела и ухудшается общее состояние ребенка.
Эти все признаки характерны для всех бактериальных инфекций горла, но так как гемолитический стрептококк самый распространенный пиогенный возбудитель, который поражает верхние дыхательные пути и ротоглотку, думать в первую очередь нужно о нем.
Уже потом врач определит точный диагноз. Главное – заподозрить бактериальную инфекцию, и вылечить ее до конца.
Врачи подчеркивают, что инфекции, вызванные стрептококками, требуют внимательного подхода к диагностике и лечению. Эти бактерии могут вызывать различные заболевания горла, включая ангину, которая проявляется сильной болью, отеком и покраснением слизистой. Специалисты рекомендуют не заниматься самолечением, а обращаться к врачу при первых симптомах. В большинстве случаев лечение включает антибиотики, которые помогают быстро справиться с инфекцией и предотвратить осложнения. Важно завершить курс лечения, даже если симптомы исчезли, чтобы избежать рецидивов. Кроме того, врачи советуют поддерживать иммунную систему, употребляя витамины и следя за режимом дня. Правильный подход к лечению стрептококковых инфекций способствует быстрому выздоровлению и снижает риск хронических заболеваний.

Клиническое течение и диагностика
Симптомы будут зависеть от места, где именно локализирован гемолитический стрептококк.
-
Если гемолитические стрептококки в горле выбрали себе для поражения миндалины, будет развиваться гнойная ангина, ее основные симптомы будут включать:
температура тела выше субфебрильной, может достигать 40 градусов;
- острая боль при глотании;
- при осмотре, миндалины могут быть в белую точечку, в гнойниках;
- полный отказ ребенка от приема пищи, сильную боль вызывает даже питье воды;
- отечность лица и шеи;
- увеличение подчелюстных и заушных лимфатических узлов.
-
В случае, когда гемолитический стрептококк поражает горло, развивается гнойный фарингит, его основные симптомы:
- сухой и болезненный кашель без отхождения мокроты;
- острая боль, особенно при глотании;
- выраженная общая интоксикация, субфебрильная температура тела, а у ребенка может достигать 39-40 градусов;
- при осмотре слизистая горла отекшая и ярко красная;
- увеличенные лимфатические узлы.
После определения симптомов, необходимо лабораторно подтвердить стрептококки в горле, с помощью таких диагностических методов:
Общий анализ крови. Он даст возможность подтвердить наличие бактериальной инфекции. Признаки: повышенная скорость оседания эритроцитов (СОЭ), лейкоцитоз за счет нейтрофильной фракции, сдвиг формулы влево.
- Посев из ротоглотки. Этот способ помогает выделить возбудителя.
- Посев на чувствительность к антибиотикам. Анализ дает расшифровку, как лечить ребенка или взрослого: к каким антибиотикам гемолитический стрептококк устойчив, а какими можно лечить.
Стоит также упомянуть об осложнениях. К ним относятся:
- пневмония;
- ларингит;
- отит;
гайморит;
- менингит.
Это все были ранние осложнения, они возникают на фоне неадекватной терапии, или же ее отсутствия.
Но есть и ряд так называемых поздних осложнений. Они возникают далеко не у всех.
Точнее сказать, недостаточно переболеть ангиной, нужно иметь некую предрасположенность, чтобы развились такие заболевания, как:
- ревматизм;
- различные пороки сердца;
- острый гломерулонефрит.
Терапия
Главное лечение – антибиотики. При лечении стрептококковой инфекции горла используют такие группы этих препаратов:
синтетические пенициллины;
- цефалоспорины третьего поколения;
- макролиды.
Подбор антибиотика и его дозу осуществляется лечащим врачом. Лечение ими длится от семи до десяти дней.
Ни в коем случае нельзя пропускать приемы препаратом, или совмещать его с алкоголем. В таком случае стрептококки станут резистентными к лечению, и потребуется лечить более новыми классами антибиотиков.
Помимо этиологического лечения, которым в данном случае являются антибиотики, следует придерживаться таких рекомендаций:
-
Пить большое количество жидкости, комнатной температуры или чуть теплой. Это могут быть слабые чаи, компоты, минеральные воды. А вот от кислых напитков лучше отказаться – они будут раздражать и так воспалившуюся слизистую горла.
Объем жидкости должен быть не меньшим чем тридцать миллилитров на килограмм веса больного. У ребенка количество жидкости должно быть большим. С каждым повышенным градусом тела добавляйте 10 мл жидкости на килограмм веса.
-
Не нужно постоянно лежать, двигайтесь по квартире. Это будет профилактикой такой болезни, как пневмония.
Ведь когда человек лежит, легкие полноценно не расправляются и не дренируются, и начинается воспаление легких, пневмония.
- Откажитесь на время от курения и острой пищи. Горло в это время нужно лечить, а не раздражать.
- Следите за питанием больного ребенка, он может полностью отказаться от пищи, что может привести к развитию ацетонемического синдрома.
- Полощите горло отваром ромашки, или аптечными антисептиками. Это поможет антибиотикам быстрее провести свое лечение.
Болезни горла, особенно те, что вызваны стрептококками, вызывают много обсуждений среди людей. Многие отмечают, что симптомы, такие как боль при глотании и покраснение горла, могут значительно ухудшить качество жизни. Важно понимать, что стрептококковая инфекция требует своевременного лечения, чтобы избежать осложнений. Люди делятся опытом использования антибиотиков, которые часто назначают врачи, и подчеркивают, что важно завершить курс лечения, даже если симптомы исчезли. Некоторые предпочитают дополнительно использовать народные средства, такие как полоскания с солью или травяные настои, чтобы облегчить дискомфорт. Однако большинство согласны, что консультация с врачом — это первый шаг к выздоровлению. Правильная диагностика и лечение помогают не только справиться с болезнью, но и предотвратить ее повторное возникновение.

Принципы профилактики
Всем хорошо известно, что заболевание куда легче предупредить, чем потом думать, что с ним делать. Вся профилактика должна быть направлена на повышение уровня иммунитета. Основные способы профилактики:
- Здоровое питание, с правильно сбалансированным количеством белков, углеводов и жиров, микроэлементов с витаминами.
Физическая активность. Не обязательно покупать дорогие курсы занятий в тренажерных залах, утренней зарядки и пешей прогулки будет вполне достаточно для укрепления иммунной системы и стенок сосудов.
-
Прием препаратов, укрепляющих иммунитет. Самым ярким примером является Immunity. Он создан на основе природных компонентов, таких как барсучий жир, экстракт одуванчика, чабреца, девясила, водорослей и других.
Он не опасен, и подходит для применения как для детей, так и для взрослых. Учеными доказано, что он способен снизить существенно вероятность заболевания острыми респираторными вирусными и бактериальными инфекциями.
- Употребление фруктов. Диетологи утверждают, что для крепкого организма, в день необходимо съедать три разных фрукта.
Как вы сами видите, предупредить болезнь можно простыми и доступными способами.
Иващенко Аня, 8 лет. Поступила в педиатрическое терапевтическое отделение. Предварительный диагноз: ОРВИ, гнойный фарингит. Жалобы на слабость, температуру тела 38,4 градуса. При осмотре задняя стенка горла красная, с белыми пустулами. В общем анализе крови повышено СОЭ, нейтрофильный лейкоцитоз.
Назначено лечение: Амоксиклав 500 мг два раза в сутки, Супрастин по 1 таблетке в день, полоскание горла раствором Хлорфилипта.
Амоксиклав – антибиотик широкого спектра действия, относится к препаратам пенициллинового ряда. Имеет в составе клавуленовую кислоту, которая защищает его от ферментов, выделяемых бактериями.
Вопрос-ответ
Чем лечить горло при стрептококковой инфекции?
Если фарингит вызван стрептококком группы А, его необходимо пролечить, особенно у детей и молодых людей, с помощью пенициллина или аналогичных препаратов, например, амоксициллина. Лечение должно длиться не менее 10 дней, иначе инфекция не будет полностью уничтожена и возрастет риск возникновения резистентности.
Какой антибиотик от стрептококка в горле?
Препаратами выбора для лечения острых форм БГСА-тонзиллита и фарингита являются пенициллины (амоксициллин, бензатин-пенициллин, феноксиметилпенициллин) и цефалоспорины I поколения (цефадроксил), а при непереносимости β-лактамных антибиотиков – макролиды (спирамицин, азитромицин, рокситромицин, кларитромицин).
Какой антибиотик эффективен при стрептококке?
Пенициллин или амоксициллин являются антибиотиками выбора для лечения фарингита, вызванного стрептококком группы А.
Чем лечится стрептококковый фарингит?
Препаратами выбора для лечения стрептококковых инфекций горла являются пенициллин или амоксициллин.
Советы
СОВЕТ №1
Обязательно проконсультируйтесь с врачом при первых симптомах инфекции горла, таких как боль, покраснение или отек. Самолечение может привести к осложнениям, поэтому важно получить профессиональную оценку состояния.
СОВЕТ №2
При стрептококковой инфекции следуйте предписаниям врача и завершайте курс антибиотиков, даже если симптомы исчезли. Это поможет предотвратить рецидив и развитие устойчивости бактерий к лечению.
СОВЕТ №3
Увлажняйте воздух в помещении и пейте много жидкости, чтобы облегчить симптомы и ускорить процесс выздоровления. Теплые напитки, такие как чай с медом или лимоном, могут помочь успокоить раздраженное горло.
СОВЕТ №4
Избегайте контакта с другими людьми, пока не закончите курс лечения, чтобы предотвратить распространение инфекции. Также старайтесь не делиться личными предметами, такими как посуда или полотенца, чтобы снизить риск заражения.

 Больной испытывает выраженную слабость во всем теле.
Больной испытывает выраженную слабость во всем теле.
 температура тела выше субфебрильной, может достигать 40 градусов;
температура тела выше субфебрильной, может достигать 40 градусов;
Общий анализ крови. Он даст возможность подтвердить наличие бактериальной инфекции. Признаки: повышенная скорость оседания эритроцитов (СОЭ), лейкоцитоз за счет нейтрофильной фракции, сдвиг формулы влево.
Общий анализ крови. Он даст возможность подтвердить наличие бактериальной инфекции. Признаки: повышенная скорость оседания эритроцитов (СОЭ), лейкоцитоз за счет нейтрофильной фракции, сдвиг формулы влево. гайморит;
гайморит; синтетические пенициллины;
синтетические пенициллины; Не нужно постоянно лежать, двигайтесь по квартире. Это будет профилактикой такой болезни, как пневмония.
Не нужно постоянно лежать, двигайтесь по квартире. Это будет профилактикой такой болезни, как пневмония.
 Физическая активность. Не обязательно покупать дорогие курсы занятий в тренажерных залах, утренней зарядки и пешей прогулки будет вполне достаточно для укрепления иммунной системы и стенок сосудов.
Физическая активность. Не обязательно покупать дорогие курсы занятий в тренажерных залах, утренней зарядки и пешей прогулки будет вполне достаточно для укрепления иммунной системы и стенок сосудов.







